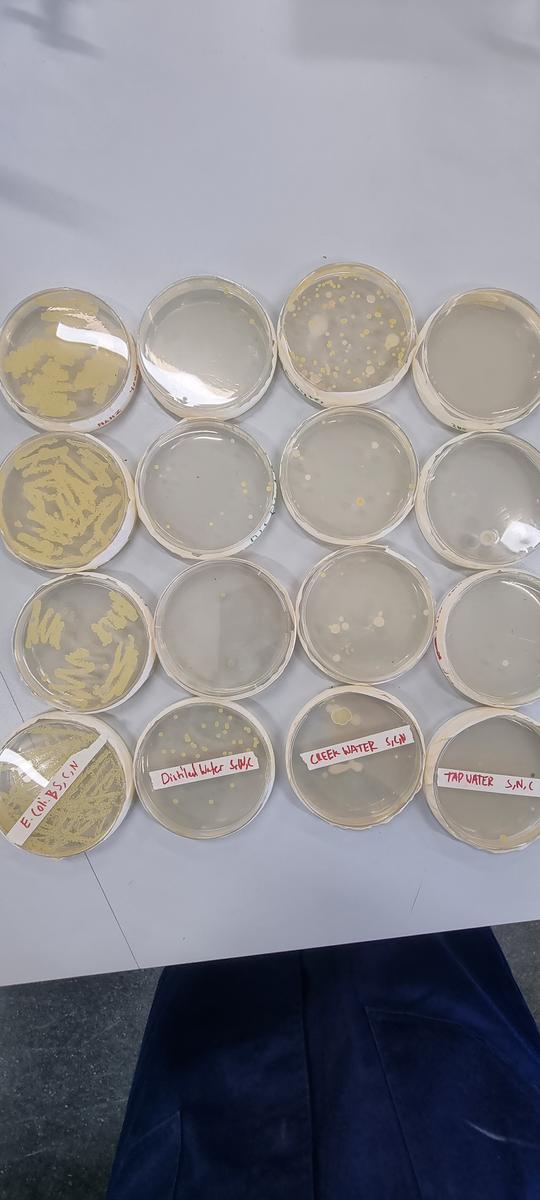

Around The College

Year 12 Environmental Science
Our Year 12 Environmental Science class was busy last week carrying out a qualitative analysis of the Scotchmans creek water. Students tested various physical and chemical indicators such as the turbidity, pH. The presence of E. coli was also tested by comparing the growth of bacterial colonies using creek water, tap water and mineralised water samples. The class concluded that the creek water was healthy after a thorough analysis of their results.
The class has been learning about the various principles of Ecologically Sustainable Development, including waste disposal and minimisation.
Year 11 Environmental Science
In our Year 11 Environmental Science class, students have been practising to apply the ‘Systems Thinking’ approach to solve environmental issues.
In one of the recent lessons, students investigated the importance of light in photosynthesis. Students compared the presence of starch in the leaves of the plant placed in light to those placed in light using iodine.
Year 10 Environmental Science
Our Year 10 Environmental Science class recently compared their oral presentations on various energy resources. Students have started building model wind turbines using STELR equipment to investigate the electricity generated with varying number of blades on the wind turbines.
Nominate Brentwood to win $5000
Win yourself a $500 Coles gift voucher and $5000 for Brentwood!
The Brentwood Green Team is seeking parent and staff support in nominating Brentwood SC to the Master Chef’s ‘Nominate your school’ competition and help us win $5000. If successful with the nomination, the funds will be used to purchase rainwater tanks for the college. The more nominations we put in, the greater chances for Brentwood to win it. Thank you in advance for your support.
Nominate Brentwood here: https://10play.com.au/masterchef/win/nominate-your-school-to-win-5000/c210412gaire
Master Chef 2021 contestants: https://10play.com.au/masterchef/participants
Monash Women’s Business Network Event: More Women in Stem
The Monash Women’s Business lunch was a networking event held at Eastern Innovation, focusing on advancing women’s representation in STEM (science, technology, engineering and mathematics). During the event guest speaker, Professor Elizabeth Croft, an internationally respected robotics researcher and Dean of the Faculty of Engineering at Monash University, shared insights on encouraging women to participate in research and employment across the wide variety of STEM fields.
The event began with a networking activity, in which randomly assigned groups were tasked with assigning female scientists, engineers and technologist to their invention. This gave the audience a chance to understand the potential of women in STEM and appreciate the contribution that they have already made to the world. While mingling with other attendees, it was a great opportunity to, as students aspiring towards careers in STEM, meet real people in the STEM and business industries and learn about their journeys, struggles, achievements, and goals.
While enjoying the lunch and deserts, Professor Elizabeth Croft began sharing her insights into the challenging and rewarding world of STEM. The audience was immediately faced with shocking statistics, demonstrating that despite recent advances towards equality, the field of engineering is still only made up of 13% women. The causation of this was explained with more statistics, conveying that despite achieving nearly identical grades to their male peers, female students feel that they are not ‘smart enough’ to become engineers – nearly 50% of female students either feel that engineering is too hard, or that they are not good enough at mathematics or science to do it.
Evidently, more needs to be done to encourage and assure young girls that they can make a positive change to the modern world through careers in engineering. Professor Croft shared the tipping point for her in wanting to become an engineer; as a child she saw the designs for a commercial airplane and from that point she knew that she was interested in a career doing engineering. The implication was that even a small amount of exposure to the STEM industry can be enough to trigger a curiosity for STEM in women of the younger generation. She also highlighted that teachers and parents are very important in promoting a supportive environment that establishes that girls can achieve what they want in STEM. The presentation delivered by Professor Croft also included exciting STEM programs covering different aspects of engineering for students, such as the Robogals Monash program, the Monash Nova Rover program, and the Monash Human Power program. It gave an insight into the opportunities females are given in engineering and how universities are trying their best to promote this field for females. She also encouraged businesses to get involved with female engineers and students, through internships and work experience programs, such as the Co-Op program. Through this program, job opportunities for female engineers and STEM workers would also increase. Towards the end of the program, there was a 30-second elevator pitch, where three individuals would be chosen from a lucky draw and would have the opportunity to present and sell their business or school. A student, Anvita, from Brentwood was pulled out of the draw and had to present to the audience. The overall aim of the exercise was to initiate spontaneous speaking, fabrication of a story and the ability to stand in front of an unknown audience. These are social skills that are needed when working in the challenging field of STEM as a female. Overall, the Monash Women’s Business lunch was an amazing opportunity. It was incredible to socialize with many businesswomen from various backgrounds and listen to Professor Croft's inspiring and thought-provoking speech about women in STEM.
Tara and Anvita, Year 10